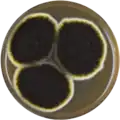
A. niger growing in a Petri dish

| Aspergillus niger | |
|---|---|
 | |
| Photomicrograph showing the conidial head of Aspergillus niger | |
 | |
| Details of the head by scanning electron microscopy | |
| Scientific classification | |
| Domain: | Eukaryota |
| Kingdom: | Fungi |
| Division: | Ascomycota |
| Class: | Eurotiomycetes |
| Order: | Eurotiales |
| Family: | Aspergillaceae |
| Genus: | Aspergillus |
| Species: | A. niger |
| Binomial name | |
| Aspergillus niger van Tieghem 1867 | |
| Synonyms | |
|
Aspergillus niger var. niger | |
Aspergillus niger is a mold classified within the Nigri section of the Aspergillus genus.[1] The Aspergillus genus consists of common molds found throughout the environment within soil and water, on vegetation, in fecal matter, on decomposing matter, and suspended in the air.[2] Species within this genus often grow quickly and can sporulate within a few days of germination.[2] A combination of characteristics unique to A. niger makes the microbe invaluable to the production of many acids, proteins and bioactive compounds. Characteristics including extensive metabolic diversity, high production yield, secretion capability, and the ability to conduct post-translational modifications are responsible for A. niger's robust production of secondary metabolites.[3] A. niger's capability to withstand extremely acidic conditions makes it especially important to the industrial production of citric acid.[1][4]
A. niger causes a disease known as "black mold" on certain fruits and vegetables such as grapes, apricots, onions, and peanuts, and is a common contaminant of food. It is ubiquitous in soil and is commonly found in indoor environments, where its black colonies can be confused with those of Stachybotrys (species of which have also been called "black mold").[5] A. niger is classified as Generally Recognized as Safe (GRAS) by the US Food and Drug Administration for use in food production,[6] although the microbe is capable of producing toxins that affect human health.[7]
Taxonomy
Aspergillus niger is included in Aspergillus subgenus Circumdati, section Nigri. The section Nigri includes 15 related black-spored species that may be confused with A. niger, including A. tubingensis, A. foetidus, A. carbonarius, and A. awamori.[8][9] In 2004, a number of morphologically similar species were described by Samson et al.[9]
In 2007, the strain of ATCC 16404 Aspergillus niger was reclassified as Aspergillus brasiliensis (refer to publication by Varga et al.[10]). This required an update to the U.S. Pharmacopoeia and the European Pharmacopoeia, which commonly use this strain throughout the pharmaceutical industry.
Cultivation

A. niger is a strict aerobe; therefore, it requires oxygen to grow.[11] The fungus can grow in a range of environmental conditions; it can grow at temperatures ranging from 6 to 47 °C.[12] As a mesophile,[13] its optimal temperature range is 35-37 °C.[11] It can tolerate pH ranging from 1.5 to 9.8.[12] A. niger is xerophilic, meaning it can grow and reproduce in environments with very little water. It can also grow in humid conditions even tolerating environments with 90-100% relative humidity.[13] The fungus is most commonly grown on potato dextrose agar (PDA), but it can grow on many different types of growth media including Czapek-Dox agar, lignocellulose agar, and several others.
Genome
Aspergillus niger has a genome consisting of roughly 34 megabases (Mb) organized into eight chromosomes.[14] The DNA contains 10,785 genes which are transcribed and translated into 10,593 proteins.[14]
| NCBI genome ID | 429 |
|---|---|
| Ploidy | haploid |
| Genome size | 34 Mb |
| Number of chromosomes | 8 |
Two strains of A. niger have been sequenced. Strain CBS 513.88 produces enzymes used in industrial applications while strain ATCC 1015 is the wildtype strain of ATCC 11414 used to produce industrial citric acid (CA).[15][16][17] The A. niger ATCC 1015 genome was sequenced by the Joint Genome Institute in a collaboration with other institutions.[18] Completed sequences have been used to uncover orthologous genes and pathways involved in fungal metabolism, specifically the catabolism of monosaccharides.[19] The ability of A. niger to change its metabolism depending on the carbon sources and other nutrients present in its environment has enabled the microorganism to survive and be found in almost all ecosystems. Further research is being done to study these mechanisms for all fungi using the complete sequenced genome of A. niger.[19]
Industrial uses
There are two ways in which Aspergillus niger can be grown for industrial purposes: solid state fermentation (SSF) and submerged fermentation (SmF).[20] SSF uses a solid substrate with nutrients and minimal moisture to grow microorganisms. Nutrients such as nitrogen and carbon come from agricultural byproducts such as wheat bran, sugar pulp, rice husks, and corn flour.[21] SSF gives better yield of microbe products and is more cost effective than SmF due to using agricultural byproducts.[22] SSF is predominantly used over SmF.[22] In SmF, microbes are grown in a liquid medium inside large aseptic fermentation vessels.[21][22] These vessels are expensive pieces of equipment that provide more water for growth and allow for tight control of environmental factors, such as temperature and pH, that affects microbial growth.[22]
Aspergillus niger is cultured to facilitate the industrial production of many substances.[23] Various strains of A. niger are used in the industrial preparation of citric acid (E330) and gluconic acid (E574); therefore, they have been deemed acceptable for daily intake by the World Health Organization.[24] A. niger fermentation is "generally recognized as safe" (GRAS) by the United States Food and Drug Administration under the Federal Food, Drug, and Cosmetic Act.[25] A. niger is also being considered as a potential new source of natural food grade pigments.[26]
The production of citric acid (CA) is achieved by growing strains of A. niger in a nutrient rich medium that includes high concentrations of sugar and mineral salts and an acidic pH of 2.5-3.5.[27] Many microorganisms produce CA, but Aspergillus niger produces more than 1 million metric tons of CA annually via a fungal fermentation process.[28] CA is in high demand for applications such as the control of microorganism growth, food and beverage flavor enhancement, acidity manipulation, pharmaceuticals, etc.[29]
A. niger produces many useful enzymes for the catabolism of biopolymers in order to obtain nutrients from its environment.[30] The production of specific enzymes can be increased for industrial purposes.[31][30] For example, A. niger glucoamylase (P69328) is used in the production of high-fructose corn syrup and pectinases (GH28) are used in cider and wine clarification. Alpha-galactosidase (GH27), an enzyme that breaks down certain complex sugars, is a component of Beano and several other products that decrease flatulence.[32] Another use for A. niger within the biotechnology industry is in the production of magnetic isotope-containing variants of biological macromolecules for NMR analysis.[33] Aspergillus niger is also cultured for the extraction of the enzyme, glucose oxidase (P13006), used in the design of glucose biosensors, due to its high affinity for β-D-glucose.[34][35]
In the food industry, A. niger is also cultured to isolate the enzyme fructosyltransferase to produce fructooligosaccharides (FOS).[36] FOS are used to manufacture low-calorie and functional foods due to FOS characteristic ability to slow growth of pathogenic microorganisms in the intestines.[36][37] These foods have prebiotic fiber among other health promoting properties. A. niger is not the only organism to produce the enzyme fructosyltransferase, but it has been found to produce the enzyme at rates conducive to industrial production.[36][37] A specific use of A. niger within the food industry is its capability to produce enzymes like carbohydrase and cellulase, which are commonly used in the seafood industry for removing the bellies of clams during processing and removing the tough external skin of shrimp from their edible internal tissue.[38]
Aspergillus niger can grow in gold-mining solutions containing cyano-metal complexes with gold, silver, copper, iron, and zinc. The fungus also plays a role in the solubilization of heavy-metal sulfides.[39] A. niger has also been shown to remediate acid mine drainage through biosorption of copper and manganese.[40]
Toxicity
A. niger produces a wide variety of secondary metabolites,[7] some of which are mycotoxins called ochratoxins,[41] such as ochratoxin A.[5][42] Contamination by filamentous fungi, such as A. niger, occurs frequently in grapes and grape based products resulting in contamination by ochratoxin A (OTA). OTA, a clinically relevant mycotoxin, can accumulate in human tissue and cause a variety of serious health conditions.[43] Potential consequences of OTA poisoning include kidney damage, kidney failure and cancer but the United States Food and Drug Administration (FDA) has not set maximum permissible levels of OTA in food unlike the EU that set maximum permissible levels in a variety of food products.[44]
Pathogenicity

Plant pathogen
Aspergillus niger can cause black mold infections in certain legumes, fruits, and vegetables such as peanuts, grapes, and onions, leading to the fungus being a common food contaminant. This filamentous ascomycete has a tolerance to changes in pH, humidity, and heat, thriving in a temperature range from 15 to 53 °C (59 to 127 °F).[45] These characteristics make infections of A. niger a common cause of post-harvest decay in fruits and vegetables, which can lead to significant economic loss in the food industry.[46] A. niger infection in plants can cause a reduction in seed germination, seedling emergence, root elongation, and shoot elongation, causing the plant to perish before maturation.[46] Specifically, Aspergillus niger causes sooty mold on onions and ornamental plants.
Human pathogen
A. niger is pathogenic. Aspergillosis is a fungal infection caused by spores of indoor and outdoor Aspergillus mold species.[47] Due to the ubiquitous nature of A. niger, its spores are commonly inhaled by humans from their surrounding environment.[48] Aspergillosis infection customarily occurs in people with compromised immune systems or pre-existing lung conditions like asthma and cystic fibrosis.[47] Types of aspergillosis include allergic bronchopulmonary aspergillosis (ABPA), allergic aspergillus sinusitis, azole-resistant aspergillus fumigatus, cutaneous (skin) aspergillosis, and chronic pulmonary aspergillosis.[47] Out of the approximated 180 species of aspergillus molds, roughly 40 species have been found to cause health concern in immunocompromised humans.[47] Aspergillosis is particularly frequent among horticultural workers who often inhale peat dust, which can be rich in Aspergillus niger spores. The fungus has also been found in ancient Egyptian mummies and can be inhaled when they are disturbed.[49] Otomycosis, which is a superficial fungal infection of the ear canal, is another disorder that can be caused by overgrowth of Aspergillus molds like A. niger.[50] Otomycosis caused by A. niger is frequently associated with mechanical damage of the ear canal's external skin barrier and often presents itself in patients living in tropical climates.[50][42] A. niger is rarely reported to cause pneumonia compared to other Aspergillus species, such as Aspergillus flavus, Aspergillus fumigatus, and Aspergillus terreus.[51]
Gallery
A. niger growing in a Petri dish
A. niger growing in a Petri dish
See also
References
- 1 2 Ellena V, Seekles SJ, Vignolle GA, Ram AF, Steiger MG (September 2021). "Genome sequencing of the neotype strain CBS 554.65 reveals the MAT1-2 locus of Aspergillus niger". BMC Genomics. 22 (1): 679. doi:10.1186/s12864-021-07990-8. PMC 8454179. PMID 34548025.
- 1 2 Curtis L (2020), "Aspergillus", Salem Press Encyclopedia of Health, Salem Press, retrieved 2022-10-18
- ↑ Kurt T, Marbà-Ardébol AM, Turan Z, Neubauer P, Junne S, Meyer V (August 2018). "Rocking Aspergillus: morphology-controlled cultivation of Aspergillus niger in a wave-mixed bioreactor for the production of secondary metabolites". Microbial Cell Factories. 17 (1): 128. doi:10.1186/s12934-018-0975-y. PMC 6102829. PMID 30129427. S2CID 52053640.
- ↑ Behera BC (November 2020). "Citric acid from Aspergillus niger: a comprehensive overview". Critical Reviews in Microbiology. 46 (6): 727–749. doi:10.1080/1040841X.2020.1828815. PMID 33044884. S2CID 222319687.
- 1 2 Samson RA, Houbraken J, Summerbell RC, Flannigan B, Miller JD (2001). "Common and important species of fungi and actinomycetes in indoor environments". Microorganisms in Home and Indoor Work Environments. CRC. pp. 287–292. ISBN 978-0415268004.
- ↑ Singh, Nikita; Gaur, Smriti (2021), Dai, Xiaofeng; Sharma, Minaxi; Chen, Jieyin (eds.), "GRAS Fungi: A New Horizon in Safer Food Product", Fungi in Sustainable Food Production, Fungal Biology, Cham: Springer International Publishing, pp. 27–37, doi:10.1007/978-3-030-64406-2_3, ISBN 978-3-030-64406-2, S2CID 234175577, retrieved 2022-11-16
- 1 2 Frisvad JC, Møller LL, Larsen TO, Kumar R, Arnau J (November 2018). "Safety of the fungal workhorses of industrial biotechnology: update on the mycotoxin and secondary metabolite potential of Aspergillus niger, Aspergillus oryzae, and Trichoderma reesei". Applied Microbiology and Biotechnology. 102 (22): 9481–9515. doi:10.1007/s00253-018-9354-1. PMC 6208954. PMID 30293194.
- ↑ Klich MA (2002). Identification of common Aspergillus species. Utrecht, The Netherlands, Centraalbureau voor Schimmelcultures. ISBN 978-90-70351-46-5.
- 1 2 Samson, RA, Houbraken JA, Kuijpers AF, Frank JM, Frisvad JC (2004). "New ochratoxin A or sclerotium producing species in Aspergillus section Nigri" (PDF). Studies in Mycology. 50: 45–6.
- ↑ Varga J, Kocsubé S, Tóth B, Frisvad JC, Perrone G, Susca A, et al. (August 2007). "Aspergillus brasiliensis sp. nov., a biseriate black Aspergillus species with world-wide distribution". International Journal of Systematic and Evolutionary Microbiology. 57 (Pt 8): 1925–1932. doi:10.1099/ijs.0.65021-0. PMID 17684283.
- 1 2 Costa CP, Gonçalves Silva D, Rudnitskaya A, Almeida A, Rocha SM (June 2016). "Shedding light on Aspergillus niger volatile exometabolome". Scientific Reports. 6 (1): 27441. Bibcode:2016NatSR...627441C. doi:10.1038/srep27441. PMC 4893740. PMID 27264696.
- 1 2 Semova N, Storms R, John T, Gaudet P, Ulycznyj P, Min XJ, et al. (February 2006). "Generation, annotation, and analysis of an extensive Aspergillus niger EST collection". BMC Microbiology. 6 (1): 7. doi:10.1186/1471-2180-6-7. PMC 1434744. PMID 16457709.
- 1 2 "Aspergillus niger". INSPQ (in Spanish). Retrieved 2022-11-17.
- 1 2 "Aspergillus niger (ID 429) - Genome - NCBI". www.ncbi.nlm.nih.gov. Retrieved 2022-10-18.
- ↑ "Home - Aspergillus niger NRRL3". mycocosm.jgi.doe.gov. Retrieved 2022-10-18.
- ↑ Andersen MR, Salazar MP, Schaap PJ, van de Vondervoort PJ, Culley D, Thykaer J, et al. (June 2011). "Comparative genomics of citric-acid-producing Aspergillus niger ATCC 1015 versus enzyme-producing CBS 513.88". Genome Research. 21 (6): 885–897. doi:10.1101/gr.112169.110. PMC 3106321. PMID 21543515.
- ↑ Pel HJ, de Winde JH, Archer DB, Dyer PS, Hofmann G, Schaap PJ, et al. (February 2007). "Genome sequencing and analysis of the versatile cell factory Aspergillus niger CBS 513.88". Nature Biotechnology. 25 (2): 221–231. doi:10.1038/nbt1282. hdl:1887/67447. PMID 17259976.
- ↑ "Home – Aspergillus niger ATCC 1015 v4.0".
- 1 2 Aguilar-Pontes MV, Brandl J, McDonnell E, Strasser K, Nguyen TT, Riley R, et al. (September 2018). "The gold-standard genome of Aspergillus niger NRRL 3 enables a detailed view of the diversity of sugar catabolism in fungi". Studies in Mycology. 91: 61–78. doi:10.1016/j.simyco.2018.10.001. PMC 6231085. PMID 30425417.
- ↑ Mrudula S, Murugammal R (July 2011). "Production of cellulose by Aspergillus niger under submerged and solid state fermentation using coir waste as a substrate". Brazilian Journal of Microbiology. 42 (3): 1119–1127. doi:10.1590/S1517-838220110003000033 (inactive 1 August 2023). PMC 3768773. PMID 24031730.
{{cite journal}}: CS1 maint: DOI inactive as of August 2023 (link) - 1 2 Pandey A, Selvakumar P, Soccol CR, Nigam P (1999). "Solid state fermentation for the production of industrial enzymes". Current Science. 77 (1): 149–162. ISSN 0011-3891. JSTOR 24102923.
- 1 2 3 4 Doriya K, Jose N, Gowda M, Kumar DS (2016). "Solid-State Fermentation vs Submerged Fermentation for the Production of l-Asparaginase". Advances in Food and Nutrition Research. 78: 115–135. doi:10.1016/bs.afnr.2016.05.003. ISBN 9780128038475. PMID 27452168.
- ↑ Cairns TC, Nai C, Meyer V (2018). "How a fungus shapes biotechnology: 100 years of Aspergillus niger research". Fungal Biology and Biotechnology. 5: 13. doi:10.1186/s40694-018-0054-5. PMC 5966904. PMID 29850025.
- ↑ Max B, Salgado JM, Rodríguez N, Cortés S, Converti A, Domínguez JM (October 2010). "Biotechnological production of citric acid". Brazilian Journal of Microbiology. 41 (4): 862–875. doi:10.1590/S1517-83822010000400005. PMC 3769771. PMID 24031566.
- ↑ "Inventory of GRAS Notices: Summary of all GRAS Notices". US FDA/CFSAN. 2008-10-22. Archived from the original on 11 October 2008. Retrieved 2008-10-31.
- ↑ Toma MA, Nazir KH, Mahmud MM, Mishra P, Ali MK, Kabir A, et al. (June 2021). "Isolation and Identification of Natural Colorant Producing Soil-Borne Aspergillus niger from Bangladesh and Extraction of the Pigment". Foods. 10 (6): 1280. doi:10.3390/foods10061280. PMC 8227025. PMID 34205202.
- ↑ Papagianni M (2007-05-01). "Advances in citric acid fermentation by Aspergillus niger: biochemical aspects, membrane transport and modeling". Biotechnology Advances. 25 (3): 244–263. doi:10.1016/j.biotechadv.2007.01.002. PMID 17337335.
- ↑ Baker SE (September 2006). "Aspergillus niger genomics: past, present and into the future". Medical Mycology. 44 (1): S17–S21. doi:10.1080/13693780600921037. PMID 17050415. S2CID 50631.
- ↑ Sackett D (2014). Citric Acid: Occurrence, Biochemistry, Applications and Processing. Nova Science Publishers Inc. p. 119. ISBN 978-1-63117-237-3.
- 1 2 Pel HJ, de Winde JH, Archer DB, Dyer PS, Hofmann G, Schaap PJ, et al. (February 2007). "Genome sequencing and analysis of the versatile cell factory Aspergillus niger CBS 513.88". Nature Biotechnology. 25 (2): 221–231. doi:10.1038/nbt1282. hdl:1887/67447. PMID 17259976. S2CID 19831590.
- ↑ Ong LG, Abd-Aziz S, Noraini S, Karim MI, Hassan MA (2004). "Enzyme production and profile by Aspergillus niger during solid substrate fermentation using palm kernel cake as substrate". Applied Biochemistry and Biotechnology. 118 (1–3): 73–79. doi:10.1385/ABAB:118:1-3:073. PMID 15304740. S2CID 19063403.
- ↑ Di Stefano M, Miceli E, Gotti S, Missanelli A, Mazzocchi S, Corazza GR (January 2007). "The effect of oral alpha-galactosidase on intestinal gas production and gas-related symptoms". Digestive Diseases and Sciences. 52 (1): 78–83. doi:10.1007/s10620-006-9296-9. PMID 17151807. S2CID 35435660.
- ↑ MacKenzie DA, Spencer JA, Le Gal-Coëffet MF, Archer DB (April 1996). "Efficient production from Aspergillus niger of a heterologous protein and an individual protein domain, heavy isotope-labelled, for structure-function analysis". Journal of Biotechnology. 46 (2): 85–93. doi:10.1016/0168-1656(95)00179-4. PMID 8672288.
- ↑ Staiano M, Bazzicalupo P, Rossi M, D'Auria S (December 2005). "Glucose biosensors as models for the development of advanced protein-based biosensors". Molecular BioSystems. 1 (5–6): 354–362. doi:10.1039/b513385h. PMID 16881003.
- ↑ Ghoshdastider U, Wu R, Trzaskowski B, Mlynarczyk K, Miszta P, Gurusaran M, Viswanathan S, Renugopalakrishnan V, Filipek S (2015). "Nano-Encapsulation of Glucose Oxidase Dimer by Graphene". RSC Advances. 5 (18): 13570–78. doi:10.1039/C4RA16852F. S2CID 55816037.
- 1 2 3 Mao S, Liu Y, Yang J, Ma X, Zeng F, Zhang Z, et al. (July 2019). "Cloning, expression and characterization of a novel fructosyltransferase from Aspergillus niger and its application in the synthesis of fructooligosaccharides". RSC Advances. 9 (41): 23856–23863. Bibcode:2019RSCAd...923856M. doi:10.1039/C9RA02520K. PMC 9069702. PMID 35530578.
- 1 2 Guo W, Yang H, Qiang S, Fan Y, Shen W, Chen X (2016-07-01). "Overproduction, purification, and property analysis of an extracellular recombinant fructosyltransferase". European Food Research and Technology. 242 (7): 1159–1168. doi:10.1007/s00217-015-2620-x. ISSN 1438-2385. S2CID 86927574.
- ↑ "CFR - Code of Federal Regulations Title 21". www.accessdata.fda.gov. Retrieved 2022-11-16.
- ↑ Singh H (2006). Mycoremediation: Fungal Bioremediation. John Wiley & Sons. p. 509. ISBN 978-0470050583.
- ↑ Soleimanifar H, Doulati AF, Marandi R (2012-06-01). "Bio-Remediation of Acid Mine Drainage in the Sarcheshmeh Porphyry Copper Mine by Fungi: Batch and Fixed Bed Process". International Journal of Mining and Geo-Engineering. 46 (1): 87–103. doi:10.22059/ijmge.2012.51321. ISSN 2345-6930.
- ↑ Abarca ML, Bragulat MR, Castellá G, Cabañes FJ (July 1994). "Ochratoxin A production by strains of Aspergillus niger var. niger". Applied and Environmental Microbiology. 60 (7): 2650–2652. Bibcode:1994ApEnM..60.2650A. doi:10.1128/AEM.60.7.2650-2652.1994. PMC 201698. PMID 8074536.
- 1 2 Schuster E, Dunn-Coleman N, Frisvad JC, Van Dijck PW (August 2002). "On the safety of Aspergillus niger--a review". Applied Microbiology and Biotechnology. 59 (4–5): 426–435. doi:10.1007/s00253-002-1032-6. PMID 12172605. S2CID 26113037.
- ↑ Freire L, Guerreiro TM, Pia AK, Lima EO, Oliveira DN, Melo CF, et al. (October 2018). "A quantitative study on growth variability and production of ochratoxin A and its derivatives by A. carbonarius and A. niger in grape-based medium". Scientific Reports. 8 (1): 14573. Bibcode:2018NatSR...814573F. doi:10.1038/s41598-018-32907-z. PMC 6167359. PMID 30275502.
- ↑ Ráduly, Zsolt; Szabó, László; Madar, Anett; Pócsi, István; Csernoch, László (2020). "Toxicological and Medical Aspects of Aspergillus-Derived Mycotoxins Entering the Feed and Food Chain". Frontiers in Microbiology. 10: 2908. doi:10.3389/fmicb.2019.02908. ISSN 1664-302X. PMC 6962185. PMID 31998250.
- ↑ Dania VO, Fajemisin AO, Azuh VO (2021-12-14). "Morphological and molecular characterization of Aspergillus niger causing postharvest rot of white yam (Dioscorea rotundata Poir)". Archives of Phytopathology and Plant Protection. 54 (19–20): 2356–2374. doi:10.1080/03235408.2021.1983365. ISSN 0323-5408. S2CID 244606795.
- 1 2 Tawfik E, Alqurashi M, Aloufi S, Alyamani A, Baz L, Fayad E (January 2022). "Characterization of Mutant Aspergillus niger and the Impact on Certain Plants". Sustainability. 14 (3): 1936. doi:10.3390/su14031936.
- 1 2 3 4 "Aspergillosis | Types of Fungal Diseases | Fungal Diseases | CDC". www.cdc.gov. 2021-05-10. Retrieved 2022-10-26.
- ↑ "Information for Healthcare Professionals | Aspergillosis | Types of Fungal Diseases | Fungal Diseases | CDC". www.cdc.gov. 2022-07-11. Retrieved 2022-10-26.
- ↑ Handwerk, Brian (May 6, 2005) Egypt's "King Tut Curse" Caused by Tomb Toxins?. National Geographic.
- 1 2 Javidnia J, Ghotbi Z, Ghojoghi A, Solhjoo K, Alshahni MM, Jeddi SA, et al. (June 2022). "Otomycosis in the South of Iran with a High Prevalence of Tympanic Membrane Perforation: A Hospital-Based Study". Mycopathologia. 187 (2–3): 225–233. doi:10.1007/s11046-022-00626-9. PMID 35347533. S2CID 247776123.
- ↑ Person AK, Chudgar SM, Norton BL, Tong BC, Stout JE (July 2010). "Aspergillus niger: an unusual cause of invasive pulmonary aspergillosis". Journal of Medical Microbiology. 59 (Pt 7): 834–838. doi:10.1099/jmm.0.018309-0. PMC 3052473. PMID 20299503.